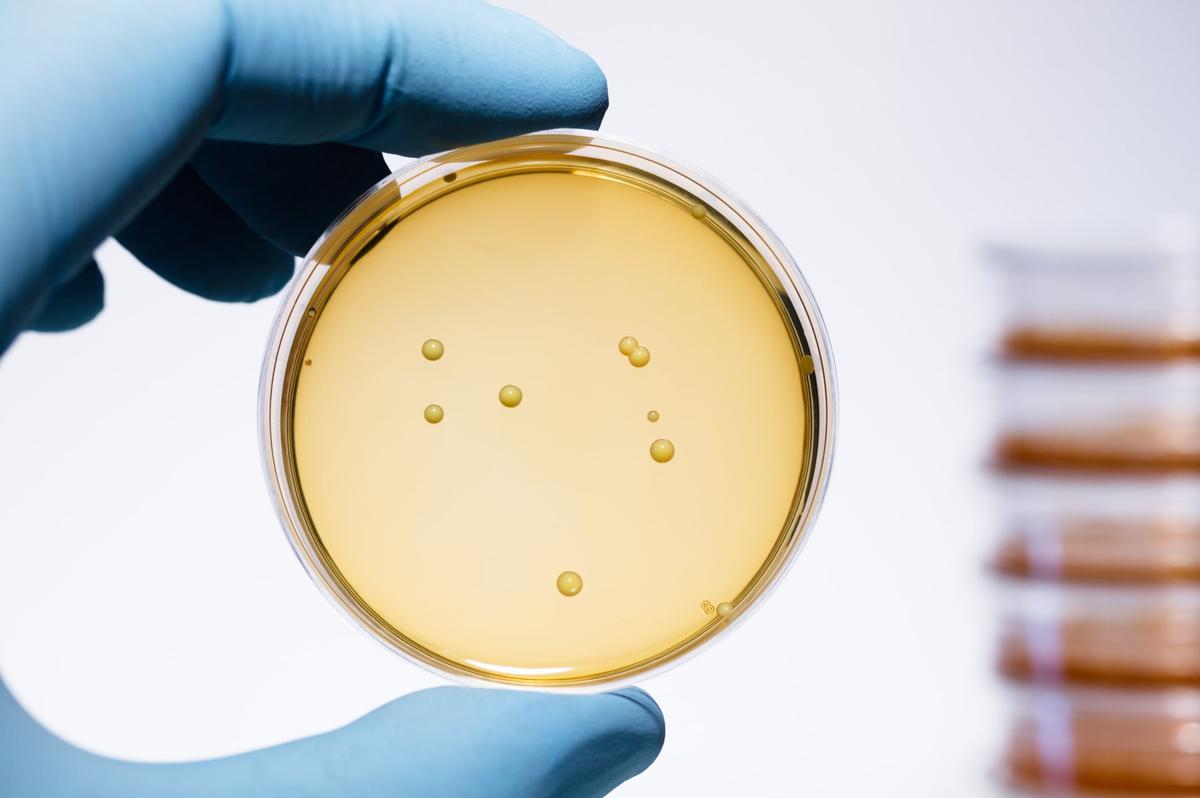
Vidya Launches US Probiotic Facility Targeting Strain Stability with Split Production Model

New Charity Commission Powers Could Suppress Advocacy and Campaigning, Culture Secretary Warned
The UK government’s Protecting What Matters strategy proposes expanding the Charity Commission’s authority to suspend trustees and shut down charities deemed to be linked to extremist abuse. A coalition of 18 charities and voluntary‑sector bodies wrote to Culture Secretary Lisa Nandy warning that vague definitions of extremism could stifle legitimate advocacy and campaigning. They urged transparent consultation and robust safeguards to prevent misuse of the new powers. The Department for Culture, Media and Sport responded that safeguards and appeal rights will be built into the proposals.
High Crude Oil Prices: 3 Integrated Energy Stocks to Bet on Right Away
Rising crude prices above $90 a barrel are boosting earnings for integrated oil majors, positioning Exxon Mobil, Chevron and BP as the sector’s top picks. The Zacks Oil & Gas Integrated International industry ranks #3, placing it in the top 1%...

NAB 2026: NAB Show 2026 to Feature Expanded AI, Sports, and Creator Economy Programming
The National Association of Broadcasters (NAB) Show 2026 will run April 18‑22 at the Las Vegas Convention Center, featuring over 1,100 exhibitors. AI programming is set to nearly double from the previous year, with two dedicated AI pavilions and participation...
Hope’s Highlights Impact-Rated Windows & Doors
Hope’s Windows, Inc., the leading U.S. maker of custom steel and bronze fenestration, is spotlighting its hurricane‑ and impact‑rated window and door systems. The company continuously tests its products to meet IBC, IRC, FBC and Miami‑Dade County standards, ensuring they...

Lacoste Serves Summer Pop-Up in Four Frasers Locations
Lacoste has launched a summer pop‑up experience in four Frasers department stores—Meadowhall, Belfast, Glasgow and Norwich—running through May 5. The temporary spaces recreate a tennis‑court atmosphere and showcase the brand’s SS26 collection alongside the newly released Elite Active trainer. Design elements...

UMG’s Michael Nash Takes Aim at ‘False Narrative of Artist Replacement’ by AI – and 3 Other Things We Learned...
Universal Music Group’s EVP and chief digital officer Michael Nash joined Splice CEO Kakul Srivastava at the HumanX AI conference to outline UMG’s AI strategy. He highlighted a growing roster of AI partners—including BandLab, Nvidia and the newly announced Splice...

DMWF Spotlight: The Full-Funnel Performance Marketing Strategy Every Brand Needs in 2026
In 2026 marketers are merging awareness and conversion into a single full‑funnel strategy, leveraging first‑party data and AI to replace the lost third‑party cookie ecosystem. Real‑time customer insights enable brands to craft coherent journeys that span social, search and email....
Sony Enters the Esports OLED Monitor Race with a Fnatic Collaboration
Sony has entered the high‑end esports monitor market with the Inzone M10S II, a 27‑inch OLED display co‑developed with esports powerhouse Fnatic. The monitor offers a dual‑mode panel—native 1440p at 540 Hz or 1080p at 720 Hz—targeting ultra‑fast competitive play. Priced at $1,099.99,...
Movers & Shakers: PRG, Live Nation, Icon Concerts
Production Resource Group (PRG) named Darren Pfeffer its first chief commercial officer, tasking him with global revenue growth and client expansion. Live Nation hired Chris Marking as EVP of international venue sponsorship to steer naming‑rights deals across a pipeline of...

2027 Toyota Crown Signia
Toyota’s 2027 Crown Signia enters the midsize hybrid SUV segment with a starting price of roughly $46,000 and a top‑end around $51,000. It pairs a 2.5‑liter four‑cylinder engine with three electric motors to produce 240 hp and achieves an EPA‑rated 38 mpg combined....

New HBO Series Spotlights American Free Soloist Dean Potter in The Dark Wizard: A Review
HBO’s new four‑part documentary series “The Dark Wizard” launches with the episode “The Death Consequence,” chronicling legendary American free‑soloist Dean Potter. Directed by Peter Mortimer and Nick Rosen of Sender Films, the episode blends archival footage and interviews to showcase...

Ohio Begins Distributing $65M in PFAS Settlement Funds to Impacted Communities
Ohio has begun disbursing the first $65 million of its $110 million settlement with DuPont to fund drinking‑water projects in PFAS‑affected communities. The money will finance treatment systems, new water sources, and connections of private wells to public networks, targeting over 75,000...
Middle East War Accelerates Regional Cross-Border Cooperation
War in the Middle East forced a surge of ocean cargo into Gulf ports, overwhelming land transport. In response, GCC countries accelerated cross‑border cooperation, slashing customs approvals from months to days and expanding real‑time coordination among ports. The UN‑mandated TIR...

76% of U.S. Companies Were Subjected to Fraud in 2025
The Association for Financial Professionals’ 2026 Payments Fraud and Control Survey found that 76% of U.S. companies experienced attempted or actual fraud in 2025, a slight dip from 79% in 2024 but still alarmingly high. Check fraud topped the list,...
3 Leisure Stocks Showing Strength Despite Industry Headwinds
Despite macro‑level headwinds—persistent inflation, higher interest rates and rising labor costs—the leisure and recreation services sector has delivered solid returns. Over the past year the industry outperformed its consumer‑discretionary peers, climbing 22.5% versus a 7.2% sector gain, while trading at...

Iran War, Indonesia Curbs to Support Nickel Price: Report
BMI raised its 2026 refined nickel price forecast to $16,600 per tonne, up from $15,800, citing a structurally firmer market despite a persistent global surplus. Indonesia’s decision to cap nickel ore mining quotas at 260‑270 million wet metric tonnes, down from...

Sebi Allows 50% Tweak in IPO Size, Offers Six-Month Relief Amid Volatility
The Securities and Exchange Board of India (SEBI) announced a six‑month window allowing companies to increase or decrease their IPO size by up to 50 % without filing fresh draft offer documents, provided the issue is slated before 30 Sept 2026. The relief...

Audit: Big Tech Often Ignores CA Privacy Law Opt-Out Requests
An independent WebXray audit of 7,634 California‑origin sites found that Google, Meta and Microsoft routinely ignore Global Privacy Control (GPC) opt‑out signals, violating the California Consumer Privacy Act (CCPA). Google showed the highest non‑compliance, failing to honor GPC requests on...
PDI Picks – 4/13/2026
The first quarter of 2026 recorded the most prolific private‑credit fundraising in the past five years, according to Private Debt Investor data. Pensions, insurers and other institutional investors are actually stepping up their commitments to the asset class. This institutional...
8 Systems Restructuring C-Suites in 2026
Eight U.S. health systems are reshaping their C‑suite structures in 2026, favoring role expansions and internal consolidations over widespread layoffs. Leaders at Huntington Health, Texas Health Resources, Vandalia Health, Cleveland Clinic, Centra Health, Sentara Halifax, Erlanger and Prime Healthcare have...

Artemis II Crew Returns to Houston
NASA’s Artemis II crew returned to Houston on April 11, 2026 after a nearly 10‑day lunar flyby, landing at Ellington Airport near Johnson Space Center. The mission marked the first crewed flight of the Orion spacecraft, testing life‑support, navigation and re‑entry systems...

OneCare Prepares for Prolonged Middle East Disruption
OneCare Group warns that the Middle East conflict, which began in late February, is creating a prolonged disruption for vessels transiting the Strait of Hormuz. Seafarers stranded in the region face extended deployments, limited movement, and heightened safety concerns for...

Rethinking Cyber and Space with Joe Mazur
SpaceNews’ new podcast *Space Minds* featured an interview with Nightwing’s cyber‑space strategist Joe Mazur. Mazur discussed how cyber operations are accelerating and becoming integral to space missions, emphasizing the rise of offensive cyber capabilities. He also explained how acquisition processes...

Super Adventure Festival Returns to Guild Wars 2, With New Loot, Homestead Music, and More for 2026
ArenaNet has revived the Super Adventure Festival in Guild Wars 2 for the 2026 season, re‑introducing the retro‑themed Super Adventure Box near Magustan Court Waypoint. Players can explore two new worlds, an expanded World 3 test zone, and a sequential Test Zone 2 after...

UK PM Starmer Says ‘Not Going to Yield’ to Trump’s Mideast War Threats
British Prime Minister Keir Starmer told parliament he will not be dragged into the Iran war, despite President Donald Trump’s threat to dismantle the UK‑US trade pact that caps U.S. tariffs at 10 percent. The dispute follows Starmer’s refusal to let...
Cava Adds Glazed Salmon to Menu
Cava announced it will add a pomegranate‑glazed salmon to its menu on April 20, marking the fast‑casual chain’s first seafood offering. The salmon can be added to custom bowls or enjoyed in two seasonal Chef Curations – the Salmon + Strawberry Sesame Bowl...

Rapidash | Pokémon Guide
Pocket Tactics’ Rapidash guide compiles every essential detail for the fire‑type horse Pokémon and its Galarian Psychic/Fairy counterpart. It lists Pokédex data, evolution level, type match‑ups, base stats, abilities, and a comprehensive move list across all game generations. The guide...
Bunker Fuel Shortages Loom After US Counter Blocks Strait of Hormuz
US naval counter‑operations have effectively blocked commercial traffic through the Strait of Hormuz, disrupting the primary route for bunker fuel shipments to Asia. Analysts warn that within two to three months container lines could encounter a global shortage of low‑sulfur...
Minnesota Community Solar Garden Program Officially Named for House Speaker Emerita Melissa Hortman
Minnesota lawmakers renamed the state’s pioneering community solar garden (CSG) program after former House Speaker Melissa Hortman, honoring her role in shaping the 2013 legislation. Governor Tim Walz signed the bill with bipartisan support, cementing her legacy in renewable‑energy policy....

From Intern to Leader with Skanska’s Dianna Barba
Dianna Barba, now a senior project engineer at Skanska, rose from an internship to leading the $1.6 billion LA Metro Purple (D Line) extension. Her career was accelerated by Skanska’s two‑year Core Competency Training Program, which rotated her through rail, bridge...

Jumeirah Burj Al Arab to Undergo Phased Restoration Programme
Jumeirah, part of Dubai Holding, announced a phased restoration of its flagship Burj Al Arab hotel. The programme will meticulously refurbish the iconic sail‑shaped resort while preserving its celebrated interior craftsmanship. Launched in 1999, the property has set global benchmarks...

Ukrainian Drones Will Be Produced in Norway
Ukrainian President Volodymyr Zelensky signed a defence‑cooperation agreement with Norway’s Prime Minister Jonas Gahr Støre, committing to produce Ukrainian‑designed drones on Norwegian soil. The pact also covers joint development of air‑defence systems, ammunition, and the training of Norwegian troops by...
Accurate Information Helps Health Systems Compete for Patient Attention
ChristianaCare’s director of patient education, Greg O'Neill, warns that health systems must adopt health‑literacy best practices or risk patients seeking answers elsewhere. The article highlights how clear communication, plain‑language materials, and proactive education can keep patients within a system’s care...
Ambience Unveils Multi-Year Roadmap to ‘Rebuild’ Healthcare with AI
Ambience Healthcare announced a multi‑year AI platform roadmap at its Apex Summit, shifting focus from documentation automation to a comprehensive intelligence layer across clinical, revenue and research workflows. The company, fresh from a $243 million Series C that lifted its valuation to...

Murphy Named to Executive Post at Crossover Media Group
John Murphy has been appointed vice president of strategic partnerships at Crossover Media Group, reuniting with former colleagues after serving as senior vice president of content monetization at Veritone. In his new role, Murphy will focus on securing fresh content...
Owner of Closed Illinois Hospitals Files Lawsuit over Eviction Notices
Resilience Healthcare, operator of the closed Weiss Memorial and West Suburban Medical Center hospitals in Chicago, filed a declaratory‑judgment lawsuit on April 14 against landlord Ramco Healthcare Holdings over eviction notices it says breach the lease. The notices demanded roughly...
Silver Demand From PV Industry Expected to Drop 19% This Year
Metal Focus’s World Silver Survey 2026 shows the global silver market remains tightly constrained, with prices averaging $40 per ounce in 2025 and a fifth straight annual deficit of 40.3 million ounces projected for 2025 and 2026. At the same time,...

Antler to Take Big Retail Step Forward with Regent St Flagship
Antler opened a flagship store on Regent Street on April 21, covering 2,400 sq ft over two floors. The design‑led space, created with Checkland Kindleysides, features natural materials, a six‑metre layered table, and a floral art installation by Hamish Powell. Lower‑ground areas convert into...

What Is CEIV Pharma?
CEIV Pharma, launched in 2014 through IATA and airport partners, provides a unified, auditable certification that consolidates GDP and other regulations for temperature‑sensitive pharmaceutical air cargo. Adoption has surged, with roughly 699 companies—including 85 airlines—certified by 2025, and a 99%...

Residential Personal Emergency Evacuation Plans: What You Need to Know
The 2025 Fire Safety (Residential Evacuation Plans) Regulations introduce Residential Personal Emergency Evacuation Plans (rPEEPs) for high‑rise residential blocks in England. Buildings with two or more domestic units that are at least 18 metres tall, seven storeys high, or over 11 metres...

Pollution Release at Chevron’s Richmond Refinery Was Triggered by a Bird
On Jan. 9, a power outage at Chevron’s Richmond refinery forced an eight‑hour flaring event that released over 3,000 pounds of sulfur dioxide. The outage was triggered when a raptor contacted a PG&E transmission line, causing a short circuit and loss...

Austria: Blaguss Integrates a Dozen Battery-Electric Coaches
Austrian bus operator Blaguss has placed twelve Yutong T12E battery‑electric coaches into regular service, initially on tour routes and slated for long‑distance lines this autumn. Each 12‑metre coach carries 47 passengers, boasts a 466 kWh battery delivering roughly 500 km of range,...

Hyundai and Kia Want To Sell You a Pickup Truck by 2030
Hyundai announced it will roll out a body‑on‑frame pickup truck in the United States before 2030, following a concept SUV that hints at a rugged design. A week later Kia confirmed it will also launch its own body‑on‑frame truck by...

Why TikTok Is the New Battleground for FMCG Sales
TikTok Shop is emerging as a dedicated social‑commerce channel for fast‑moving consumer goods, leveraging its discovery‑led format to turn viral videos into purchases. Ninety‑three percent of users engage with the shop feature and 88 % discover new brands, while a two‑click...
Candy Crush Maker King on AI Use, Layoffs, Workplace Culture – and the Competition
King’s live‑operations VP Eva Ryott explained how AI assists level design for Candy Crush Saga, automating testing of its 21,000 levels while keeping designers in the loop. She clarified that AI is a support tool, not a replacement, even after...

Reshaped Expectations for ULD Performance in Pharma
Unit Load Devices (ULDs) are shifting from simple cargo containers to sophisticated, temperature‑controlled assets as pharmaceutical airfreight expands. Modern ULDs now include active cooling/heating systems, advanced insulation, and real‑time telemetry to meet strict GDP and MHRA requirements for biologics, vaccines,...

Say Yes to the AI: David’s Bridal Introduces Chatbots to Help with Wedding Dress Shopping
David’s Bridal has integrated its wedding‑dress catalog into ChatGPT and Microsoft Copilot using Shopify’s agentic storefronts, allowing brides‑to‑be to describe style, budget and size and receive instant recommendations with images, pricing and ratings. The AI‑driven experience lets shoppers save favorites...

Agentic Engine Optimization: Google AI Director Outlines New Content Playbook
Google Cloud AI director Addy Osmani introduced Agentic Engine Optimization (AEO), a framework for making web content consumable by autonomous AI agents. He argues that token limits, not clicks or dwell time, now drive content performance, urging creators to front‑load...
Vidya Launches US Probiotic Facility Targeting Strain Stability with Split Production Model
Vidya has opened a 48,000‑square‑foot U.S. facility that merges manufacturing, research and development with its headquarters. The campus uniquely separates spore‑forming and non‑spore‑forming probiotic production into distinct buildings, a first in North America. The layout supports pilot, clinical and commercial...

Verdant Robotics Expands Into Grass Seed and Sod, “Where the Weeds and the Crop Can Look Nearly Identical’
Verdant Robotics has extended its SharpShooter precision‑application system to grass seed and sod production, sectors where weeds closely resemble the crop. The tractor‑mounted platform uses high‑resolution cameras and machine‑learning‑driven 3D modeling to spray herbicide on weeds as small as 2 mm...